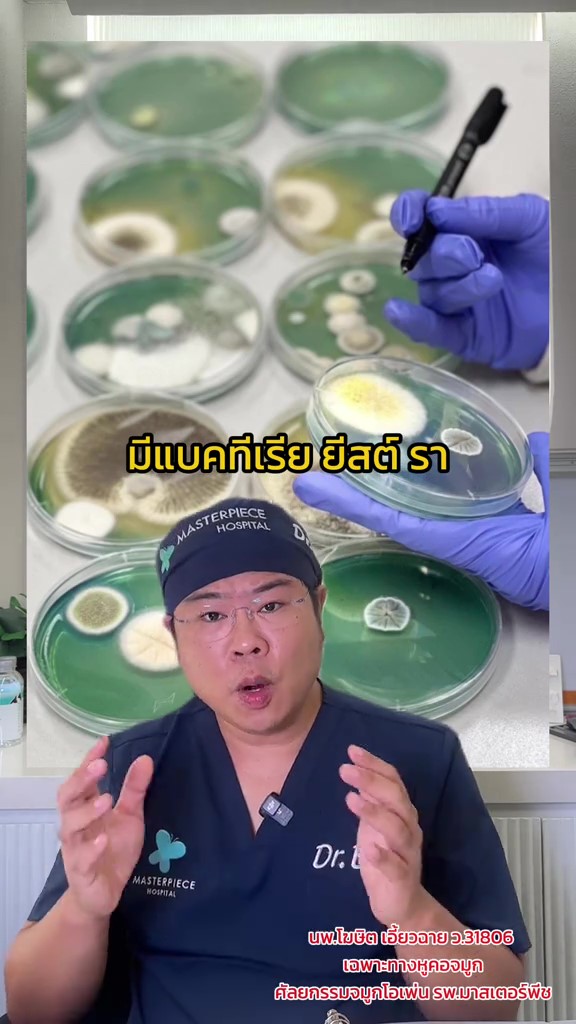

ระวังโรค! "ดินสอพองปลอม" ทำหน้าแหก-ปอดพัง หมอใช้มะนาวทดสอบ แค่บีบลงไปรู้เลย
.jpg?ip/crop/w1200h700/q80/jpg)
รู้หรือไม่? มีวิธีทดสอบ "ดินสอพองปลอม" ใช้แค่มะนาวเสี้ยวเดียว รู้ไว้ก่อนสงกรานต์ ระวังพังตั้งแต่หน้ายันปอด
หมอเบนซ์ หรือ นพ. โฆษิต เอี้ยวฉาย แพทย์ชำนาญการศัลยกรรมจมูก รพ.มาสเตอร์พีช ได้ให้ความรู้และเตือนภัยก่อนช่วงสงกรายต์ ผ่านทางช่องติ๊กต็อก @dr.benz_masterpiece ในประเด็นของ "ดินสอพอง" และอันตรายที่ควรรู้ 2 ข้อ
หลายคนอาจไม่รู้ว่า กรมวิทย์ฯ ได้ทำการทดสอบแล้วเมื่อปี 2567 ก่อนเผยข้อมูลยืนยันว่า "ดินสอพองมีเชื้อโรค 48%" ทั้งแบคทีเรีย ยีสต์ และเชื้อรา ซึ่งอาจทำให้เกิดอาการคล้ายอาหารเป็นพิษ หรือหากมีบาดแผลอยู่แล้วก่อนติดเชื้อ ก็อาจรุนแรงถึงขั้น "แบคทีเรียกินเนื้อคน"
สิ่งที่น่ากังวลไม่เพียงแค่ของแท้แต่สกปรก แต่ยังมี "ดินสอพองปลอม" ซึ่งทำมาจากผงยิปซัม หากสูดเข้าไปจะเกิดทางเดินหายใจอักเสบ และลึกลงไปได้ถึงปอดเลยทีเดียว หรือถ้าโดนใบหน้าก็จะได้รับความเสียหายอย่างแน่นอน ดังนั้น แนะนำให้เลือกดินสอพองที่มีเครื่องหมาย อย.(สำนักงานคณะกรรมการอาหารและยา) หรือโอทอป (OTOP) เพื่อความปลอดภัย
ทั้งนี้ นอกจากจุดสังเกตที่สีสันสดใสเกินจริงแล้ว คุณหมอยังแนะนำวิธีการทดสอบดินสอพอง เพียงแค่นำสารที่เป็นกรด เช่น น้ำมะนาว หรือน้ำส้มสายชู หยดลงไปบนดินสอพอง หากว่าเป็นของแท้ต้องมีฟองขึ้นมา
- หมอเฉลย ก๋วยเตี๋ยวเมนูใด "เค็มไตวาย" ของจริง โซเดียมยิ่งกว่าบะหมี่ซอง แต่คนกินไม่ค่อยรู้!
- นาทีเดียวรู้! หมอเบนซ์สอนหา "จุดบอดตา" มนุษย์ทุกคนมี ตำแหน่งที่มองไม่เห็นเลย (คลิป)

อัลบั้มภาพ 13 ภาพ
ดาวน์โหลดสนุกแอปฟรี

.jpg?ip/crop/w350h197/q80/jpg)
